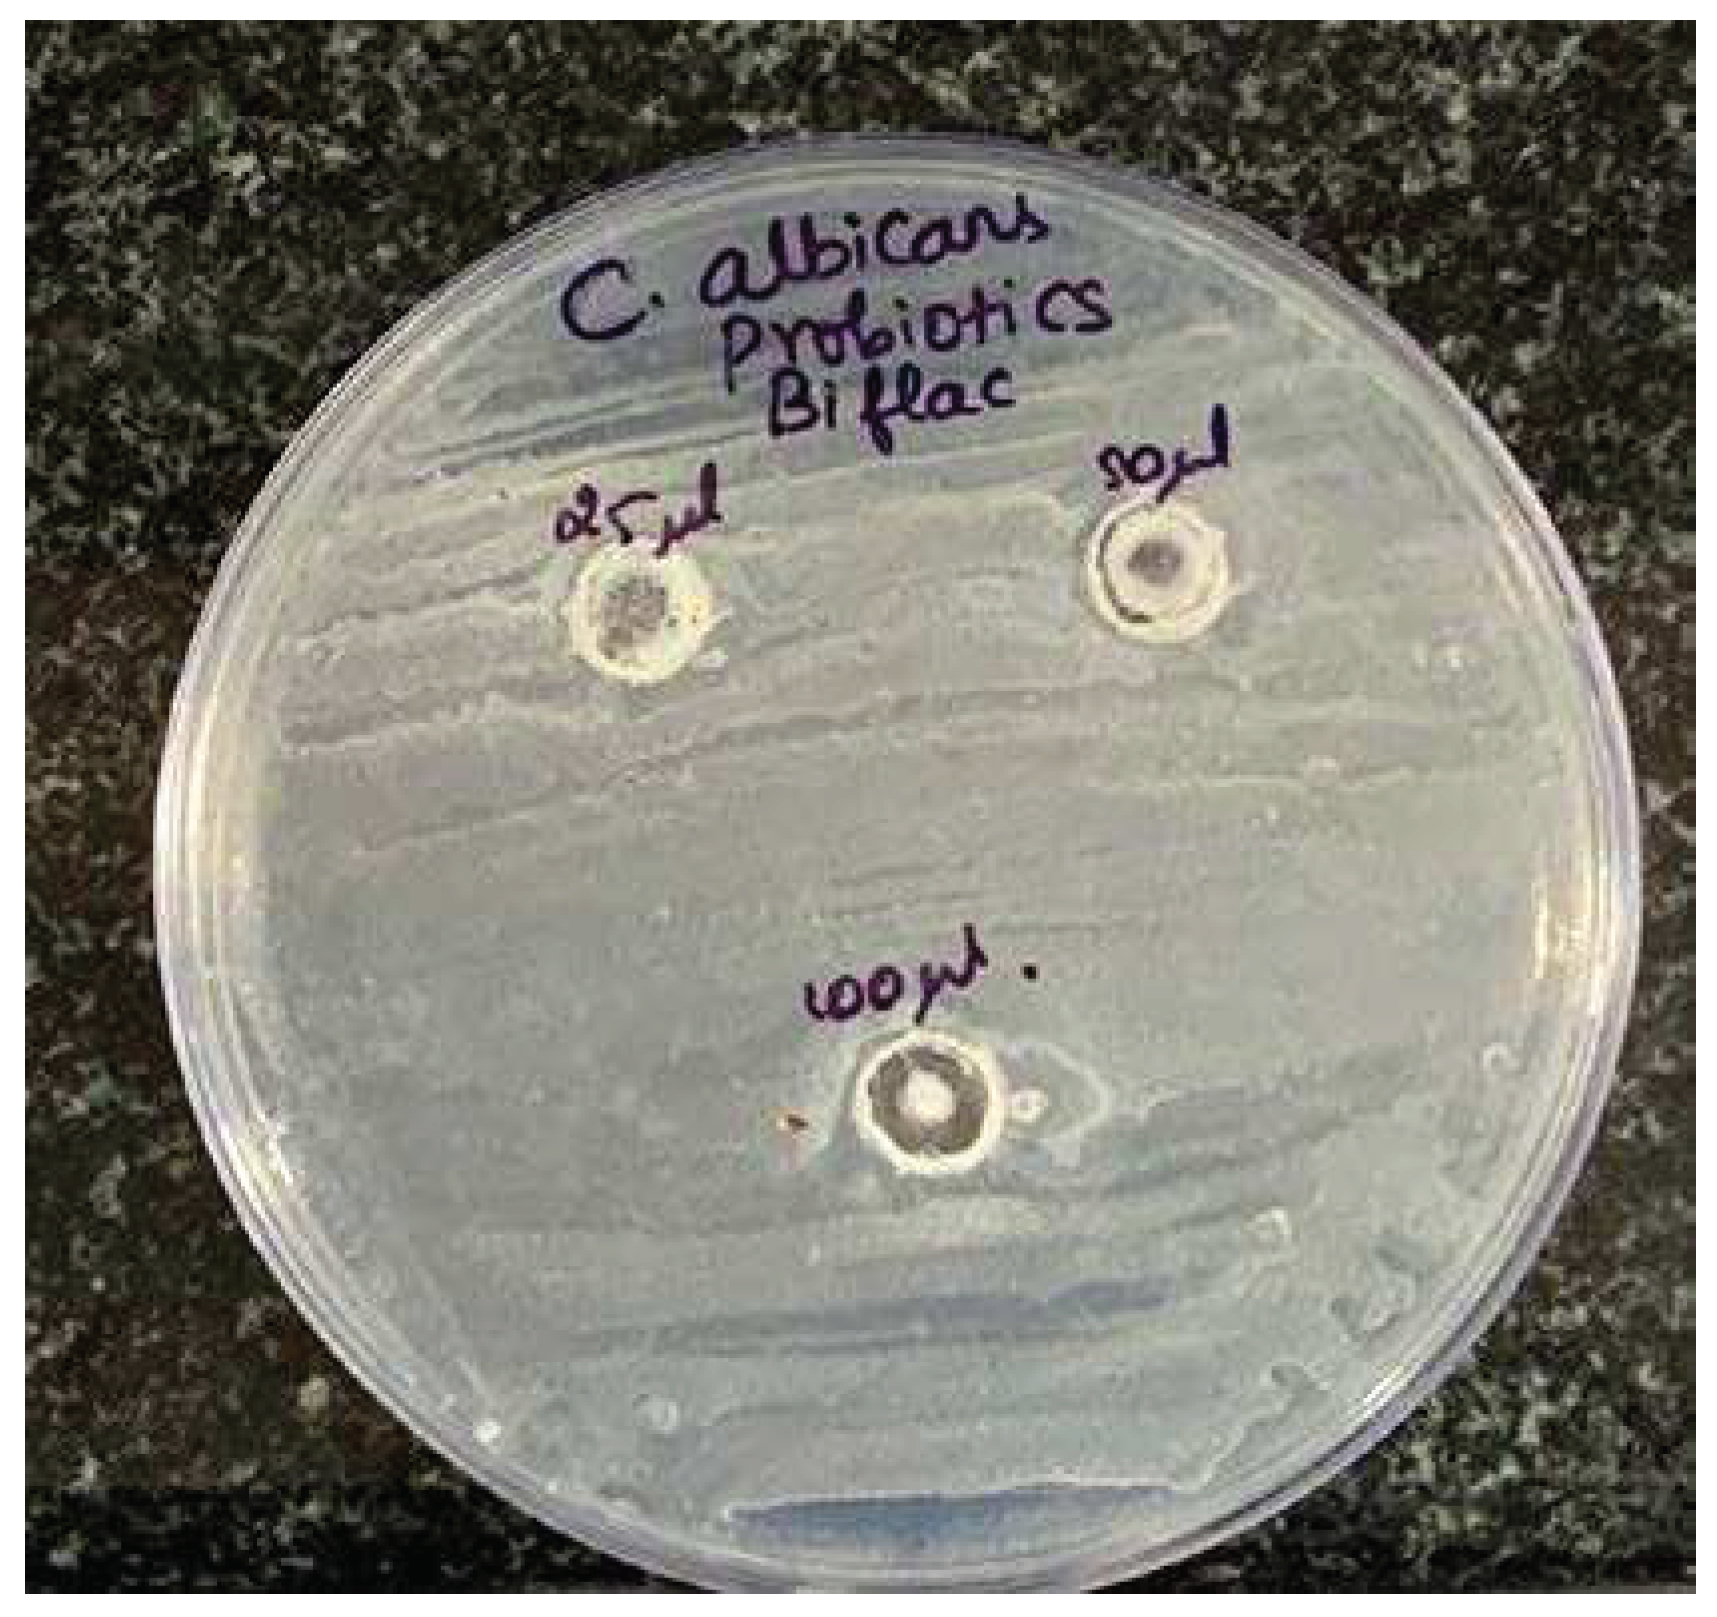
Preprints 95799 g001

Introduction
Candida
albicans is a fungus which is polymorphic and is a commensal of the human oral cavity. It has been isolated from the oral cavity of 60% of healthy individuals. C. albicans is an opportunistic pathogenic yeast that has the potential to cause local, as well as systemic infections of varied severity. Candida species can cause a fungal infection known as candidiasis which can affect the oral cavity, of which C.
albicans is the most frequent culprit [
1]. Candida
albicans is also known to have caused other diseases such as intestinal candidiasis. Recently, C.
albicans has been the center of focus due to increased incidence of candidiasis owing to a hike in the number of Acquired Immunodeficiency Syndrome (AIDS) patients, overuse of antimicrobials and modified vigorous regimes of cancer care [
2].
Probiotics are defined (by the WHO) as “Live microorganisms that, when administered in adequate amounts, confer a health benefit on the host”. Several studies have been done to show that probiotics exhibit certain levels of antimicrobial activity against multiple pathogenic strains and that they can be used to treat diseases of plants, animals and human population. Most of the studies centered around use of probiotics for diseases of the gastrointestinal tract, like acute diarrhea and inflammatory disorders of the intestine [
3]. Probiotics have also been utilized for treating conditions causing other mucocutaneous lesions including those of the vagina, respiratory and urinary tracts [
4]. Moreover, probiotics have been used in the management of infections, hypersensitivity reactions and metabolic diseases [
5].
During the past few decades, studies have reported that probiotics can also be used to maintain an optimal balance in the oral cavity. Probiotics have been proven to control the activity of oral microorganisms, more specifically inhibiting the growth of pathogens such as S.
mutans, a cariogenic bacteria and C.
albicans, the causative agent of oral candidiasis [
6]. Recently, due to development of resistance against common antifungal drugs, such as fluconazole [
7], new methods are needed for prevention and treatment of infections caused by these pathogens. Some studies have shown usage of probiotics as a prophylactic and therapeutic agent in oral candidiasis. However, the effectiveness of probiotics against oral candidiasis has not been established till date [
8]. For example, there were studies showing that consumption of a probiotic drink containing L.
casei strain, did not have any overall effect on selected oral parameters in healthy denture wearers [
9]. Available literature on the role of probiotics for the management of oral candidiasis is inconclusive and the underlying mechanism remains ambiguous. Therefore, further research on this area is imperative. Hence, the aim of this study was to compare the antifungal activity of three different probiotics against Candida
albicans.
Materials and Methods
This in vitro study was conducted in a laboratory setting and Institutional Ethics Committee approval was obtained (ethical approval number SDC/SIHEC/2020/DATA/0619-0320). 3 types of commercially available probiotics - Bifilac, Pre pro HS and VSL-3 were obtained. Preparation of solutions of these 3 probiotics were done and these solutions of 3 probiotics were loaded onto 3 separate culture plates with strain of Candida
albicans and were placed under incubation. The culture plates were incubated with Sabouraud Dextrose Agar (SDA) at 37°C. Disc diffusion testing of the 3 probiotic products were performed on 3 separate culture mediums with strains of C.
albicans. Different probiotics discs were placed onto the surface of the inoculated plates. The plates were incubated at for 48 hours, and the diameter of the zone of inhibition around the discs were measured (
Figure 1,
Figure 2 and
Figure 3)
These data were entered into the Excel sheet and were cross verified by 2 fellow researchers for confirmation of data. These data were subjected to statistical analysis. The data obtained were analyzed and was plotted in the form of bar graphs.
Results
In this study, it was found that among the three probiotic products, only Bifilac exhibited a maximum zone of inhibition of 13mm at concentration of 100µL against C. albicans (
Figure 1 and
Figure 4). VSL-3 showed a zone of inhibition of 11mm at concentrations of 100µL (
Figure 2 and
Figure 6) , while Pre pro HS showed a zone of inhibition of 11mm at concentrations of 50µL and 100µL (
Figure 3 and
Figure 5). None of the 3 probiotics showed inhibition activity in the disc diffusion assay at concentration of 25µL, whereas all 3 probiotics showed a zone of inhibition of 10mm. At 50µL, Bifilac and Pre pro HS showed a zone of inhibition of 11mm(
Figure 4 and
Figure 5), whereas VSL -3 showed only limited antifungal activity with a zone of inhibition of 10mm (
Figure 6). It was seen that Bifilac exhibited strongest anti-Candida activity with clear zones of inhibition of 13mm against C.
albicans at 100 μl , on comparison with Pre pro HS and VSL-3 (
Figure 7).
Discussion
This study used 3 commercially available probiotics : Bifilac, Pre Pro HS and VSL - 3. Composition of Bifilac consist of Lactobacillus
sporogenes (100 million), Streptococcus
faecalis (T-110), Clostridium
butyricum (TO-A 4 million), and Bacillus
mesentericus TO-A JPC 2 million [
10]. Pre pro HS capsules contain Lactobacillus
acidophilus, Lactobacillus
rhamnosus, Lactobacillus
casei, Lactobacillus
plantarum, Lactobacillus
bulgaricus, Bifidobacterium
longum, Bifidobacterium
infantis, Bifidobacterium
breve, Streptococcus
thermophilus and Fructo OligoSaccharides [
11]. The third probiotic VSL-3 consists of 8 bacterial strains: 4 strains of Lactobacillus (L
acidophilus, L
plantarum, L
casei, and L
delbrueckii subspecies
bulgaricus), 3 strains of Bifidobacterium (B
breve, B
longum, and B
infantis), and a strain of Streptococcus (S
salivarius and S
thermophilus) [
12].
Previous studies have evaluated the antifungal effects of individual bacterial strains. Some studies have shown that, probiotic strains of Lactobacilli sp. have been used for treatment and prevention of vaginal infections of fungal origin and it has been recommended for treatment of recurrent vulvovaginal candidiasis (RVCC) [
13,
14]. However, the effectiveness of probiotics in treatment of oral candidiasis is questionable. The results infer that Bifilac ,as a commercial probiotic, might possess the ability to prevent and treat oral candidiasis (
Figure 1 and
Figure 4).Inhibition of C. albicans by some strains of probiotic species is known and results of clinical trials have shown the effectiveness of some strains of probiotics in prevention of C. albicans infections [
15]. In this study, it was seen that probiotics have a significant amount of antifungal activity against C albicans. Studies by Kosgey JC et al.,[
16] and Zhao, C et al.,[
13] also reported similar effect of probiotics against C
albicans, where, among the 4 probiotics selected, only Medilac-Vita showed a clear inhibition zone against C.
albicans, while other probiotics ( Entrocoordinatibiogen, Golden Bifidobacterium tablets and Bifid Triple Viable) did not show any inhibition activity in the disc diffusion assay upon screening. A study by Salari S et al., compared the inhibitory effects of Cell-free supernatants of L.
acidophilus and L.
plantarum against five different candida species. It was found that at concentrations of 10
10 and 10
2 cfu/ml, L.
acidophilus and L.
plantarum, respectively, inhibited the growth of three species of candia except for C.
krusei and C.
albicans [
17]. However, in our study only one candidal strain was taken into consideration, as it is the most commonly involved species in oral candidiasis infection.
It is important to know that in vitro studies do pose limitations, since they can never imitate the complex microbiota that are found in the oral cavity. This indicates in-vitro studies on probiotics with varied combinations of bacterial strains are required to increase the knowledge about the role of probiotics in the prevention and management of infections caused by Candida sp., in the oral cavity.
Conclusions
This in-vitro study attempted to assess the effect of three commercially available probiotics on C. albicans. It was found that Bifilac exhibited promising antifungal activity. The other two probiotics Pre pro HS and VSL-3 also showed antifungal effect, although lower than that of Bifilac.
Within the limits of the present study, this study could prove that probiotics can be considered as an alternative treatment option for oral candidiasis. As a promising potential antifungal therapy, probiotics could surpass the resistance developed by C. albicans to conventional antifungal agents and also eliminate adverse drug effects of the latter. The results of this study may be extrapolated to conduct further in-vivo/ clinical studies to evaluate the efficacy of probiotics in patients undergoing treatment for oral candidiasis.
Funding
The present project is supported/ funded/sponsored by Saveetha Institute of Medical and Technical Sciences Saveetha Dental College and Hospitals.
Conflicts of Interest
Manthra Prathoshni performed the conception of study, data collection, data analysing and interpreting statistics and contributed to manuscript writing, discussed the results and contributed to the final manuscript. Dr Shilpa Syam contributed to the conception of study, study design, analyzed the collected data, statistics and interpretation and also critically revised the manuscript, discussed the results and contributed to the final manuscript.
References
- Coco BJ, Bagg J, Cross LJ, Jose A, Cross J, Ramage G. Mixed candida albicans and candida glabrata populations associated with the pathogenesis of denture stomatitis. Oral Microbiol Immunol. 2008, 23:377–83. [CrossRef]
- Cutler JE, Deepe GS Jr, Klein BS. Advances in combating fungal diseases: vaccines on the threshold. Nat Rev Microbiol. 2007, 5:13–28. [CrossRef]
- Verna EC, Lucak S. Use of probiotics in gastrointestinal disorders: what to recommend?. Therap Adv Gastroenterol. 2010, 3:307–19. [CrossRef]
- Shenoy A, Gottlieb A. Probiotics for oral and vulvovaginal candidiasis: a review. Dermatol Ther. 2019, 32:e12970. [CrossRef]
- Rijkers GT, Bengmark S, Enck P et al. Guidance for substantiating the evidence for beneficial effects of probiotics: current status and recommendations for future research. J Nutr. 2010, 140:671S – 676S. [CrossRef]
- Saha S, Tomaro-Duchesneau C, Daoud JT, Tabrizian M, Prakash S. Novel probiotic dissolvable carboxymethyl cellulose films as oral health biotherapeutics:in vitropreparation and characterization. Expert Opin Drug Deliv. 2013,10:1471–82. [CrossRef]
- Lopez J, Pernot C, Aho S et al. Decrease in Candida albicans strains with reduced susceptibility to fluconazole following changes in prescribing policies. J Hosp Infect. 2001, 48:122–8. [CrossRef]
- Ahola AJ, Yli-Knuuttila H, Suomalainen T, Poussa T, Ahlström A, Meurman JH, Korpela R. Short-term consumption of probiotic-containing cheese and its effect on dental caries risk factors. Arch Oral Biol. 2002,47:799–804. [CrossRef]
- Sutula J, Coulthwaite L, Thomas L, Verran J. The effect of a commercial probiotic drink on oral microbiota in healthy complete denture wearers. Microb Ecol Health Dis. 2012,23. [CrossRef]
- Elavarasu S, Suthanthiran T, Thangavelu A, Kanagaraj SS, Mohandas L, Sekar S. Evaluation of efficacy of probiotic (BIFILAC) on Porphyromonas gingivalis: In vitro study. J Pharm Bioallied Sci. 2016,8:S45-S47. [CrossRef]
- Cheng FS, Pan D, Chang B, Jiang M, Sang LX. Probiotic mixture VSL#3: an overview of basic and clinical studies in chronic diseases. World J Clin Cases. 2020, 8:1361-1384. [CrossRef]
- Pre Pro HS . Accessed : October 17,2023. Capsule. https://www.1mg.com/otc/pre-pro-hs-capsule-otc210425?wpsrc=Google+Organic+Search.
- Zhao C, Lv X, Fu J, He C, Hua H, Yan Z. In vitro inhibitory activity of probiotic products against oral Candida species. J Appl Microbiol. 2016,121:254–62. [CrossRef]
- Hilton E, Rindos P, Isenberg HD. Lactobacillus GG vaginal suppositories and vaginitis. J Clin Microbiol. 1995,33:1433–1433. [CrossRef]
- Falagas ME, Betsi GI, Athanasiou S. Probiotics for prevention of recurrent vulvovaginal candidiasis: a review. J Antimicrob Chemother. 2006,58:266–72. [CrossRef]
- Kosgey JC, Jia L, Fang Y, Yang J, Gao L, Wang J, et al. Probiotics as antifungal agents: experimental confirmation and future prospects. J Microbiol Methods. 2019,162:28–37. [CrossRef]
- Salari S, Ghasemi Nejad Almani P. Antifungal effects of Lactobacillus acidophilus and Lactobacillus plantarum against different oral Candida species isolated from HIV/ AIDS patients: an in vitro study. J Oral Microbiol. 2020,12:1769386. [CrossRef]
|
Disclaimer/Publisher’s Note: The statements, opinions and data contained in all publications are solely those of the individual author(s) and contributor(s) and not of MDPI and/or the editor(s). MDPI and/or the editor(s) disclaim responsibility for any injury to people or property resulting from any ideas, methods, instructions or products referred to in the content. |
© 2024 by the authors. Licensee MDPI, Basel, Switzerland. This article is an open access article distributed under the terms and conditions of the Creative Commons Attribution (CC BY) license (http://creativecommons.org/licenses/by/4.0/).